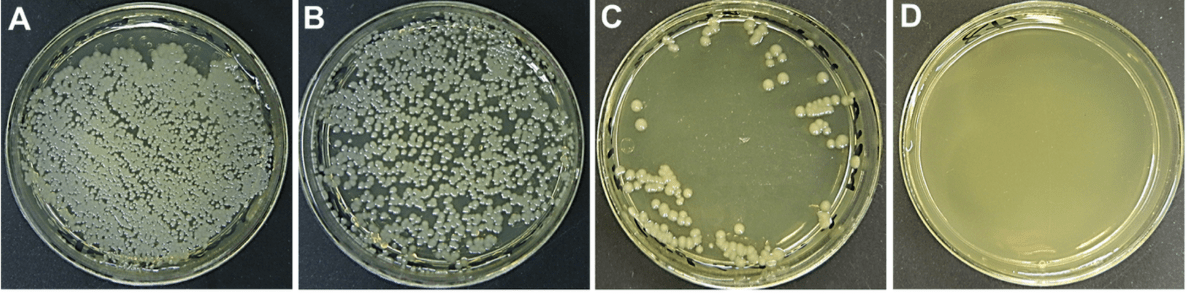

- Webcasts
- Manufacturing
- Sponsored Content
Best Practices for Aseptic Sampling from Stainless Process Equipment
January 10, 2020
Date: Jan 10, 2020
Duration: 20 Min
Sponsored Content
This webcast features: Bobbi Allen, Technical E xpert, Aseptic Sampling,
xpert, Aseptic Sampling,
Sartorius Stedim Biotech
Aseptic sampling from stainless process equipment is a regulatory requirement and can be accomplished in many ways. How samples are removed from the process stream and the containers you collect them into can have an impact not only on the integrity of the process but the accuracy and repeatability of the tests you are performing.
Emerging technologies can streamline sample taking, minimize risk to process, and improve the accuracy and precision of your qualitative and quantitative assays.
In this webinar, we review the pros and cons of common sampling methodologies as well as best practices for choosing the most appropriate sample collection vessels.
Watch the recorded webcast now.
About the Author(s)
You May Also Like





